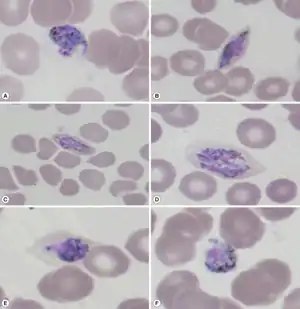

Plasmodium ovale wallikeri
| Plasmodium ovale wallikeri | |
|---|---|
![]() | |
| Plasmodium ovale trophozoite, Giemsa stain. | |
| Scientific classification | |
| Domain: | Eukaryota |
| Clade: | Diaphoretickes |
| Clade: | SAR |
| Clade: | Alveolata |
| Phylum: | Apicomplexa |
| Class: | Aconoidasida |
| Order: | Haemospororida |
| Family: | Plasmodiidae |
| Genus: | Plasmodium |
| Species: | |
| Subspecies: | P. o. wallikeri |
| Trinomial name | |
| Plasmodium ovale wallikeri Sutherland, et al. 2010 | |
Plasmodium ovale wallikeri is a subspecies of parasitic protozoa that causes tertian malaria in humans. The subspecies was described in 2010 when it was established that the two subspecies of Plasmodium ovale, while morphologically identical are genetically distinct.[1]
Phylogenetics
a-f)Giemsa-stained thin blood smears show different life-cycle stages of Plasmodium ovale wallikeri
This species separated from its closest known relative - Plasmodium ovale curtisi - between 1.0 and 3.5 million years ago.
Clinical features
Clinical features for P. ovale wallikeri are the same as Plasmodium ovale.
Epidemiology
Plasmodium ovale wallikeri has been identified in Ghana, Myanmar, Nigeria, São Tomé, Sierra Leone and Uganda.
References
- ↑ Sutherland CJ, Tanomsing N, Nolder D, Oguike M, Jennison C, Pukrittayakamee S, Dolecek C, Hien TT, do Rosário VE, Arez AP, Pinto J, Michon P, Escalante AA, Nosten F, Burke M, Lee R, Blaze M, Otto TD, Barnwell JW, Pain A, Williams J, White NJ, Day NP, Snounou G, Lockhart PJ, Chiodini PL, Imwong M, Polley SD (2010). "Two nonrecombining sympatric forms of the human malaria parasite Plasmodium ovale occur globally". J Infect Dis. 201 (10): 1544–50. doi:10.1086/652240. PMID 20380562.
This article is issued from Wmcloud. The text is licensed under Creative Commons - Attribution - Sharealike. Additional terms may apply for the media files.
